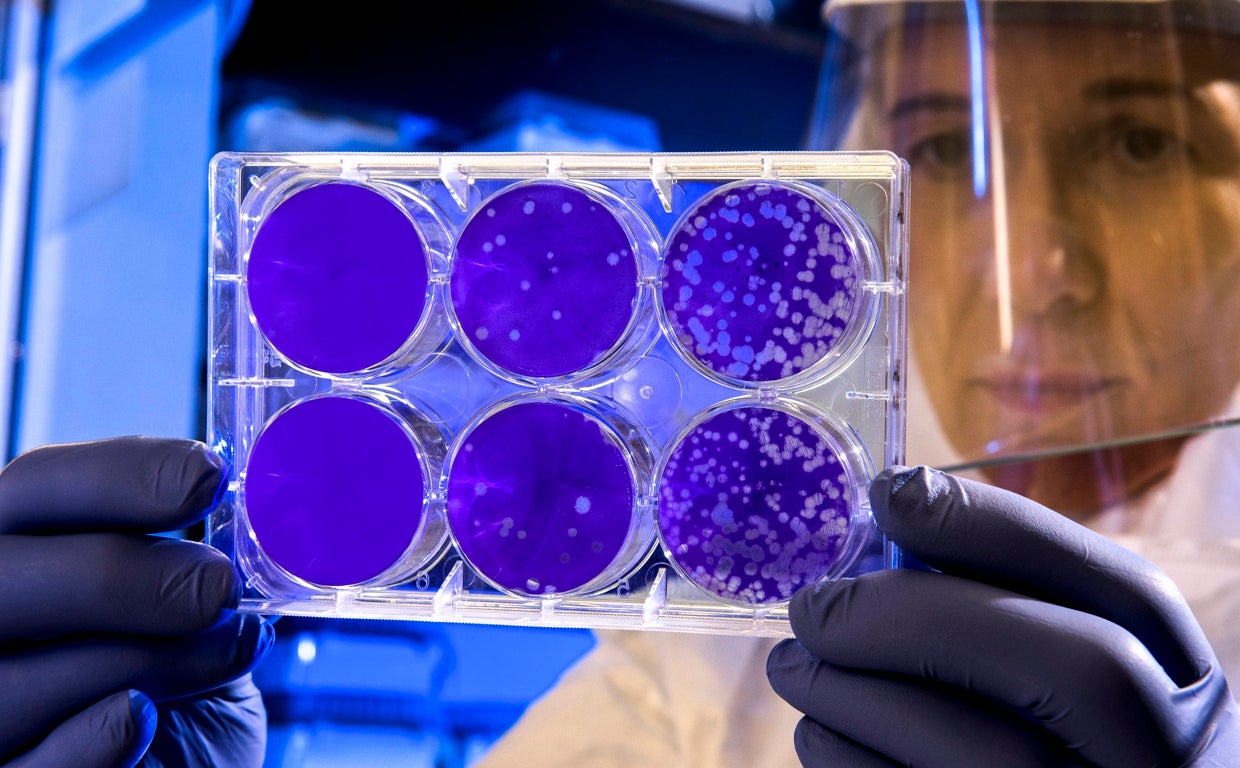
Pruebas de covid

Un fármaco contra el cáncer podría salvar la vida a los pacientes hospitalizados con Covid-19
Un medicamento experimental utilizado para combatir el cáncer podría reducir el riesgo de muerte de los pacientes de Covid-19 en aproximadamente un 55%, sugiere un nuevo estudio
R.I.
Madrid
El fármaco, sabizabulina, ha resultado eficaz para ayudar a los pacientes de Covid-19 gravemente enfermos, más que los medicamentos autorizados anteriormente, informan los investigadores en la revista «The New England Journal of Medicine».
Veru, la empresa desarrolladora del fármaco con sede en ... Miami, ha solicitado a la Administración de Alimentos y Medicamentos de EE.UU. una autorización de emergencia. La aprobación proporcionaría otra vía de tratamiento para los pacientes hospitalizados.
«Esto parece superimpresionante», declaró al New York Times el Ilan Schwartz, experto en enfermedades infecciosas de la Universidad de Alberta (Canadá). «Tenemos un pequeño número de tratamientos para pacientes con enfermedades graves que mejoran la mortalidad, pero otro tratamiento que pueda reducir aún más las muertes sería muy bienvenido».
Sin embargo, el tamaño de la muestra del estudio fue relativamente pequeño, ya que sólo se administró el fármaco a 134 pacientes.
«En general, creo que es muy emocionante, aunque me gustaría que se realizaran estudios confirmatorios más amplios e independientes», dijo Schwartz, que no participó en el estudio.
El fármaco impide que las células construyan las conexiones moleculares destinados a transportar materiales de una zona de la célula a otra.
La sabizabulina fue desarrollada inicialmente por investigadores de la Universidad de Tennessee para combatir el cáncer cortando este tipo de acceso a la autopista entre las células tumorales, impidiendo su rápido crecimiento.
El fármaco parece funcionar en los pacientes con Covid-19 al reducir la inflamación pulmonar, que puede ser mortal
Pero el fármaco parece funcionar en los pacientes con Covid-19 al reducir la inflamación pulmonar, que puede ser mortal.
El ensayo incluyó a pacientes que estaban hospitalizados para el tratamiento del Covid-19 y que recibían oxígeno o ventilación mecánica. Tenían otros factores de riesgo, como la obesidad o la hipertensión, que contribuían a su alto riesgo de morir por la enfermedad. Por ello, se les permitió ser tratados con otros medicamentos, como esteroides como la dexametasona, que se dice que reduce el riesgo de muerte por Covid-19 en un tercio.
Pero de los 134 voluntarios que tomaron el fármaco y los 70 que recibieron un placebo, las tasas de mortalidad de los dos grupos eran drásticamente diferentes después de 60 días. Más del 45% del grupo que recibió el placebo murió en comparación con el 20% de los que tomaron sabizabulina, lo que supone una reducción del 55% del riesgo global de muerte.
Se ha demostrado que unos pocos medicamentos antivirales mantienen a los pacientes con Covid-19 fuera del hospital, pero generalmente no funcionan bien con la Covid moderada o grave, dicen los expertos.
El Paxlovid es uno de esos fármacos que suele administrarse en la fase inicial de la enfermedad.
Veru dijo que detuvo el ensayo antes de lo previsto porque un comité asesor independiente consideró que el fármaco era tan eficaz que no sería ético seguir administrando un placebo a algunos pacientes.
Solo el 40% de los ingresados con Covid lo están a causa del virus
Patricia AbetDe los más de 800 positivos hospitalizados en Galicia esta semana, menos de la mitad lo están por problemas derivados de la infección, sino por otro tipo de patología
Añadir un antiviral al tratamiento habitual de Covid podría reducir un 30% la mortalidad en ingresados de gravedad
A. C.Un ensayo mundial sobre un nuevo medicamento, liderado desde España por el Hospital Germans Trias, mejora la clínica de pacientes con complicaciones
Esta funcionalidad es sólo para suscriptores
Suscribete
Esta funcionalidad es sólo para registrados
Iniciar sesiónEsta funcionalidad es sólo para suscriptores
Suscribete